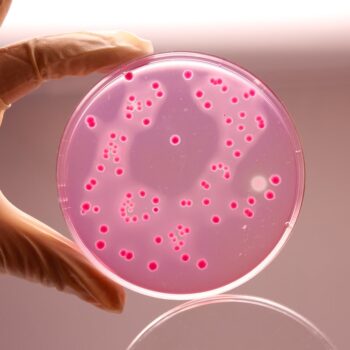
HiMedia M581 - distributed by Immunomart

-
Violet Red Bile Agar 82 CAD – 1,859 CADPrice range: 82 CAD through 1,859 CADFor Research Use Only. Not for human or animal consumption, therapeutic, or diagnostic use.
Hi-Media catalog product. Violet Red Bile Agar. Available in 4 sizes.
For Research Use Only (RUO). Not for human or veterinary consumption, therapeutic, or diagnostic use.
-
Violet Red Bile Agar (1.2%) 205 CAD – 1,859 CADPrice range: 205 CAD through 1,859 CADFor Research Use Only. Not for human or animal consumption, therapeutic, or diagnostic use.
Hi-Media catalog product. Violet Red Bile Agar (1.2%). Available in 3 sizes.
For Research Use Only (RUO). Not for human or veterinary consumption, therapeutic, or diagnostic use.
-
Violet Red Bile Agar w/ Glucose and Lact 325 CAD – 2,115 CADPrice range: 325 CAD through 2,115 CADFor Research Use Only. Not for human or animal consumption, therapeutic, or diagnostic use.
Hi-Media catalog product. Violet Red Bile Agar w/ Glucose and Lact. Available in 3 sizes.
For Research Use Only (RUO). Not for human or veterinary consumption, therapeutic, or diagnostic use.
-
Violet Red Bile Broth 205 CAD – 1,859 CADPrice range: 205 CAD through 1,859 CADFor Research Use Only. Not for human or animal consumption, therapeutic, or diagnostic use.
Hi-Media catalog product. Violet Red Bile Broth. Available in 3 sizes.
For Research Use Only (RUO). Not for human or veterinary consumption, therapeutic, or diagnostic use.
-
Violet Red Bile Glucose Agar 283 CAD – 2,486 CADPrice range: 283 CAD through 2,486 CADFor Research Use Only. Not for human or animal consumption, therapeutic, or diagnostic use.
Hi-Media catalog product. Violet Red Bile Glucose Agar. Available in 3 sizes.
For Research Use Only (RUO). Not for human or veterinary consumption, therapeutic, or diagnostic use.
-
Violet Red Bile Glucose Agar 74 CAD – 1,970 CADPrice range: 74 CAD through 1,970 CADFor Research Use Only. Not for human or animal consumption, therapeutic, or diagnostic use.
Hi-Media catalog product. Violet Red Bile Glucose Agar. Available in 4 sizes.
For Research Use Only (RUO). Not for human or veterinary consumption, therapeutic, or diagnostic use.
-
Violet Red Bile Glucose Agar w/o Lactose 267 CAD – 2,325 CADPrice range: 267 CAD through 2,325 CADFor Research Use Only. Not for human or animal consumption, therapeutic, or diagnostic use.
Hi-Media catalog product. Violet Red Bile Glucose Agar w/o Lactose. Available in 3 sizes.
For Research Use Only (RUO). Not for human or veterinary consumption, therapeutic, or diagnostic use.
-
Violet Red Bile Glucose Agar w/o Lactose 70 CAD – 2,448 CADPrice range: 70 CAD through 2,448 CADFor Research Use Only. Not for human or animal consumption, therapeutic, or diagnostic use.
Hi-Media catalog product. Violet Red Bile Glucose Agar w/o Lactose. Available in 4 sizes.
For Research Use Only (RUO). Not for human or veterinary consumption, therapeutic, or diagnostic use.
-
Violet Red Bile Glucose HiCynth Agar w/o 234 CADFor Research Use Only. Not for human or animal consumption, therapeutic, or diagnostic use.
Hi-Media catalog product. Violet Red Bile Glucose HiCynth Agar w/o.
For Research Use Only (RUO). Not for human or veterinary consumption, therapeutic, or diagnostic use.
-
Violet Red Glucose HiVeg Agar w/ La 206 CADFor Research Use Only. Not for human or animal consumption, therapeutic, or diagnostic use.
Hi-Media catalog product. Violet Red Glucose HiVeg Agar w/ La.
For Research Use Only (RUO). Not for human or veterinary consumption, therapeutic, or diagnostic use.
Proudly representing





150+ years of combined research-supply heritage